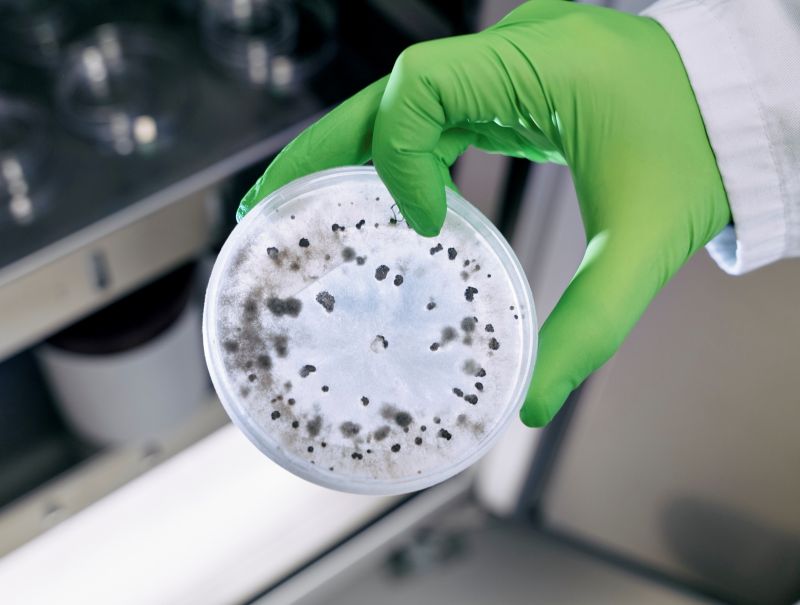
Biotalys

Confo's mission is to develop novel GPCR modulators for patients with severe and underserved diseases, with a current emphasis on rare diseases, peripheral pain and obesity.
Included in the AvH investment portfolio since 2024.
6.23 %
Beneficial interest AvH